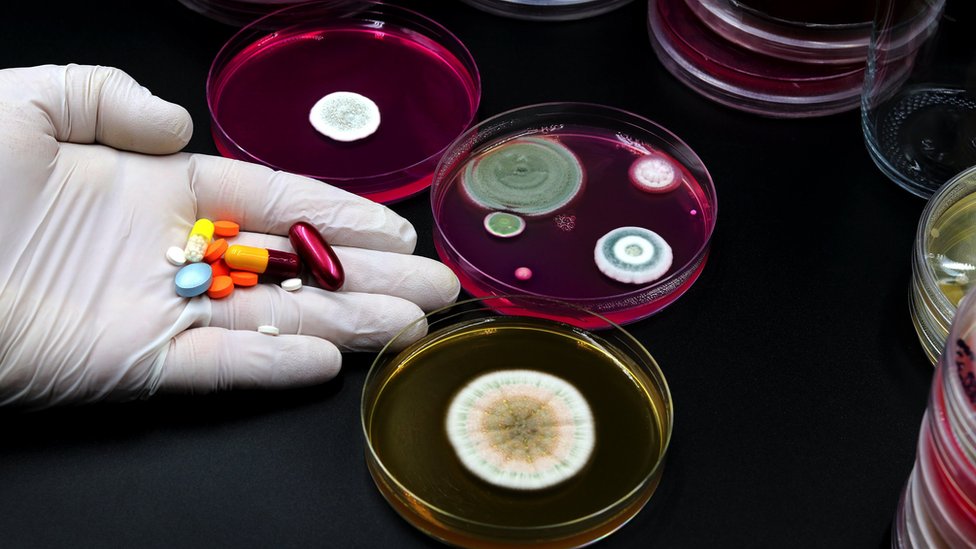

Gljivica otporna na lekove Kandida auris (C. auris) otkrivena je tek pre 15 godina, ali je već jedna od najstrašnijih bolničkih mikroba na svetu.
Ako uđe u vaše telo, ova gljivica tipa kvasca može da ugrozi krvotok, nervni sistem i nekoliko unutrašnjih organa.
Svetska zdravstvena organizacija (SZO) procenjuje da njena stopa smrtnosti varira od 30 do 53 odsto pacijenata zaraženih ovom invazivnom infekcijom.
Još više zabrinjava to što se pokazalo da je ova gljivica otporna na većinu uobičajenih antigljivičnih lekova.
Neki sojevi su rezistentni na sve lekove koje imamo na raspolaganju, kaže BBC dopisnik za zdravlje Džejms Galager.
- Misteriozna gljivica otkrivena u Brazilu zabrinjava naučnike
- The Last of Us: Da li gljivična pandemija može sve da nas pretvori u zombije
- Otkriće penicilina - od gljive do leka za milione ljudi
Prema američkim Centrima za kontrolu i prevenciju bolesti (CDC), do pojave infekcija došlo je u više od 30 zemalja.
Pregled izveštaja o slučajevima iz 2020. godine iz tih zemalja iznedrio je skoro 4.750 slučajeva u čitavom svetu između 2009. i 2019.

U saopštenju izdatom 20. marta, CDC kaže da novi podaci ukazuju na to da se gljivica „širila alarmantnom brzinom u američkim zdravstvenim ustanovama" 2020. i 2021. godine.
Klinički slučajevi u zemlji su se utrostručili - sa 476 slučajeva 2019. godine na 1.471 slučajeva 2021.
Takođe, studija iz 2019. međunarodnog tima istraživača pokazala je da je rast temperature povezan sa klimatskim promenama možda odigrao ulogu u povećanom broju infekcija Kandidom auris.
Evo svega što treba da znate o ovoj smrtonosnoj infekciji.
Šta je Kandida auris?
Kandida auris (C. auris) je kvasac, porodica gljivica koja sadrži vrste prilično korisne po ljude kad su u pitanju aktivnosti kao što su pravljenje hleba i kuvanje piva, ali koje takođe sadrže sojeve koji izazivaju infekcije kod ljudi.

Jedan primer je veoma rasprostranjena Kandida albikans, koja izaziva ustobolju, ali može da dovede i do težih infekcija.
K. auris je prvo otkrivena u ušnom kanalu jednog pacijenta u Tokijskoj gradskoj gerijatrijskoj bolnici 2009, što je inspirisalo njeno ime (auris je latinski za uvo).
Kandidini kvasci najčešće žive na našoj koži ne stvarajući probleme, ali mogu da izazovu infekcije ako smo bolesni ili ako završe na pogrešnom mestu, kao što su krvotok ili pluća.
- Šta je virus nipa koji brine naučnike
- Sve o korona virusu - u malim dozama
- Mit o „nabudženom“ imunom sistemu
Kakve bolesti izaziva?
C. auris najčešće izaziva infekciju krvotoka, ali može da utiče i na respiratorni sistem, centralni nervni sistem i unutrašnje organe, baš kao i na kožu.
Ove infekcije su obično prilično ozbiljne.
Gljivice su često otporne na uobičajene lekove, zbog čega je teško lečiti te infekcije.
„Najveći problem sa ovom gljivicom je njena otpornost na lekove koje posedujemo", kaže doktorka Tina Džoši, vanredna profesorka Molekularne biologije sa Univerzitetu u Plimutu, u Velikoj Britaniji.
„Ali drugi problem je što je prepoznavanje infekcije C. auris veoma teško i lako može da se pomeša sa drugim gljivicama, što dovodi do pogrešnog metoda lečenja."
To znači da bi pacijent mogao da bude bolestan duže vremena ili da mu se stanje pogorša pre nego što bude podvrgnut odgovarajućem lečenju.
Kako se širi?
Prenošenje je uglavnom preko kontaminiranih površina u bolnicama.
Lepi se za cevčice za infuziju i manžetne na aparatima za merenje pritiska.
Veoma ju je teško očistiti, prema doktoru Nilu Stounu, vodećem stručnjaku iz Bolnice za tropske bolesti, sa Univerzitetskog koledža u Londonu.
Rešenje je često zatvaranje čitavih bolničkih odeljenja.
„Ovo je gljivica koja najviše zabrinjava i ignorišemo je na vlastitu odgovornost", kaže doktor Stoun.
„Ona može da ugasi čitave zdravstvene sisteme."
U saopštenju izdatom 20. marta, CDC je naveo da novi podaci pokazuju kako se gljivica „širi alarmantnom brzinom" u SAD.
Da li da se zabrinem da ću dobiti infekciju?
Malo je verovatno da ćete se zaraziti sa C.auris u svakodnevnom životu.
Međutim, rizik je veći ako provodite duže vremena u bolnici ili u domu za negu starijih, a pacijenti na intenzivnoj nezi imaju mnogo više šansi da se zaraze infekcijom C. auris, prema CDC-u.

Rizik od dobijanja infekcije takođe je veći ako ste mnogo na antibioticima, zato što ti lekovi takođe uništavaju dobre bakterije koje sprečavaju ulazak C. auris u telo.
Zašto je C. auris otporna na uobičajene lekove?
Otpornost na uobičajene antigljivične lekove, kao što je flukonazol, primećena je kod većina sojeva C. auris.
To znači da ovi lekovi na rade na C. auris.
Zbog ovoga se za lečenje infekcija koriste manje uobičajeni antigljivični lekovi, ali je C. auris u međuvremenu stekla rezistenciju i na njih.
DNK dokazi pokazuju da su geni antigljivične rezistencije u C. auris veoma slični onima pronađenim kod veoma česte C. albikans.
Ovo sugeriše da se geni rezistencije možda prenose sa jedne vrste na drugu.
- Podmukla bolest koja izaziva bol u karlici žena
- Šta je Marburg virus
- Otkriven uzrok misterioznih smrti od posledica upale pluća u Argentini
Kako klimatske promene mogu biti odgovorne za veliki broj infekcija?
Studija iz 2019, objavljena u časopisu mBio Američkog mikrobiološkog društva, sugerisala je da je razlog zašto su infekcije C. auris postale toliko česte možda taj što je ova vrsta prisiljena da živi na višim temperaturama zbog klimatskih promena.
Većina gljivica više voli hladnije temperature koje se mogu naći u zemlji.
Ali, kako globalne temperature rastu, C. auris je bila prisiljena da se prilagođava na više temperature.

To je možda olakšalo gljivici da se razvije u ljudskom telu, čija je temperatura od 36 do 37 stepeni Celzijusa.
Šta može da se uradi da bi se kontrolisao broj infekcija?
Bolje razumevanje ko je najugroženiji od zaražavanja sa C. auris prvi je korak ka smanjenju broja infekcija.
„Nalazimo se iza krive kad je u pitanju proučavanje gljivice", kaže doktorka Džoši.
„Nisam uopšte iznenađena da sada moramo da se sustižemo s njom."
Zdravstveni radnici moraju da budu svesni da su ljudi koji provode duže vremenske periode u bolnicama ili domovima za negu starijih ili oni sa oslabljenim imunim sistemom ugroženiji.
Ne identifikuju sve bolnice C. auris na isti način.

Ona se ponekad pomeša sa drugim gljivičnim infekcijama, kao što je ustobolja, i prepiše joj se pogrešno lečenje.
Unapređenje dijagnoze pomoći će da se ranije identifikuju pacijenti koji imaju C. auris, što će značiti da su dobili pravi tretman - sprečivši dalje širenje infekcije na druge pacijente.
Ali iznad svega, moraju da se pojačaju napori za prevenciju infekcija, kaže doktorka Džoši.
„Glavna mera je prevencija i kontrola infekcija, zato što smo se već uverili koliko je teško izboriti se sa onim što ona uradi pacijentima."
„Bolnice moraju da pojačaju dezinfekciju i čišćenje."
Je li ovo jedina gadna gljivica koja nam preti?
Ne baš.
Na prvoj listi gljivičnih „prioritetnih patogena" svih vremena, objavljenoj u oktobru prošle godine, SZO je navela ni manje ni više nego 19 gljivica koje predstavljaju veliku pretnju po javno zdravlje.
C. auris je bila jedna od četiri gljivice koja se pojavila u grupi „kritičnog prioriteta", koju je SZO opisao kao „urođeno rezistentnu na većinu dostupnih antigljivičnih lekova".
Ovaj članak je adaptiran iz materijala Lene Sirik i Džejmsa Galagera.
Pogledajte video: Mogu li mRNK vakcine da pomognu u terapiji raka
Pratite nas na Fejsbuku,Tviteru i Vajberu. Ako imate predlog teme za nas, javite se na bbcnasrpskom@bbc.co.uk
Pogledajte još:
Preuzmi aplikaciju i prati vijesti
PRATITE NAS NA






